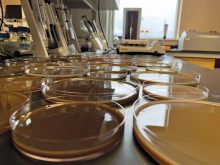
Solvent casting. PHOTOs: UNIVERSITY OF MANITOBA

“This is about
everything you do.”
– JANICE FILMON
They say infant mortality rates began to fall in Manitoba after home economists began going out to rural communities to teach homemakers about sanitation and food safety.
Agricultural extension centred mostly on farm management, growing crops and raising livestock when home economics first became a separate course of study at the University of Manitoba in 1910.
But home economists soon took their places with other agricultural specialists on so-called extension trains travelling to rural communities and carrying practical information for farm families.
Read Also

Potatoes join Innovation Farms testing ground
New MacGregor site adds potato farming to FCC and EMILI’s agriculture tech initiatives in Manitoba.
And while the field has undergone huge changes over the last 100 years, its purpose is still a direct delivery of science-based knowledge to the home, says Gustaaf Sevenhuysen, dean of the university’s faculty of human ecology.
Sevenhuysen joined staff, students and alumni September 11 in the official kickoff leading up to the faculty’s centennial celebration in 2010.
Special attention will be paid to May 3, 2010, the 100th anniversary date when the first class of home economics, then part of the Manitoba Agricultural College, came to order. Events will culminate in a gala homecoming September 23 to 26, 2010.
A look at the 1911 curriculum shows that, even back then, home economics was more than just cooking and sewing.
Units of study included home sanitation (drainage, plumbing, heating and ventilation), household handicrafts (wood finishing, varnishing, soldering and glazing), home nursing (first aid, caring for the sick), home furnishing, and record keeping.
Graduates were expected to be fully versed in all aspects of housekeeping. Last week’s meeting, which drew 150 registrants, was told only half-jokingly the real goal of home economics was to provide ideal mates for farm boys studying agriculture on the campus.
But home economics was one of the few opportunities in those days for young women to receive an academic education. The focus was always on professional training, incorporating science, engineering and medicine into practical skills that could be taken into the home, Sevenhuysen said.
From early on, child care was an important part of the program. A practicum held at a model house on campus saw students care for a “practice child” – usually an orphan or ward of the state. A nursery school was introduced in 1943.
Food and clothing are still important today. But the focus has shifted as the science developed. Food science now covers nutraceuticals, functional foods and metabolism. A medical textiles program develops protective clothing for special applications in hospitals. The sewing laboratory of 1915 has evolved into a computer-aided clothing design facility.
The faculty moved into its current location, the former horticulture building, in 1950. Home economics received faculty status in 1970. Its name changed to human ecology in 1982.
A proposed university initiative in the late 1990s to abolish the faculty was thwarted when community groups, including Keystone Agricultural Producers, protested.
Practitioners acknowledge home economics is searching for new directions in a changing world. Fewer high schools teach the subject now than they once did. People don’t sew and cook to the same extent either. Some wonder if home economics is still relevant in a world of fast food, throwaway clothes and changing social mores.
But Janice Filmon, honorary centennial committee chair and wife of former Manitoba premier Gary Filmon, believes home economics still provides essential training in basic life skills.
“The life I’ve had and how I’ve been able to mine the experiences probably found its genesis in these very basic things,” said Filmon, who graduated in 1963 and then went into social work.
“This is about everything you do.” [email protected]